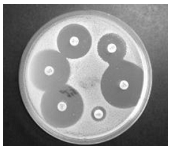
enunciado 664342-1

Foram encontradas 1.207 questões.
Texto para responder as questão a seguir.
“A legislação que regulamenta o Imposto sobre a Propriedade Predial e Territorial Urbana (IPTU) estabelece, de modo geral, que o fato gerador desse tributo para as prefeituras ocorrerá no dia 1 de janeiro de cada ano”.
Na arrecadação do exemplo apresentado, qual lançamento de natureza orçamentária deverá ser efetuado?
Provas
Questão presente nas seguintes provas
O que estabelecem as normas brasileiras de
contabilidade?
Provas
Questão presente nas seguintes provas
Um paciente que apresenta os índices de
creatinina e ureia aumentados pode estar
sofrendo
Provas
Questão presente nas seguintes provas
Um técnico deve realizar a contagem de
células presentes na urina em uma uroanálise
de rotina, essa contagem é realizada com o
auxílio de
Provas
Questão presente nas seguintes provas
- Parasitologia
- ToxicologiaProtozoologia e Helmintologia: Morfologia, Patogenia, Epidemiologia e Profilaxia
Um paciente está sob suspeita de ascaridíase,
em seu exame parasitológico de fezes. Qual
é a forma de vida que se espera encontrar
para confirmar o diagnóstico?
Provas
Questão presente nas seguintes provas
A técnica a seguir é muito utilizada na rotina microbiológica. Ela é utilizada para verificar
Provas
Questão presente nas seguintes provas
“Art. 9º O estabelecimento de saúde deve
registrar de forma sistemática a execução das
atividades de cada etapa do gerenciamento
de tecnologias em saúde.” A qual resolução
da ANVISA o enunciado se refere?
Provas
Questão presente nas seguintes provas
Um paciente entra em uma sala de coleta de
sangue de um laboratório e o profissional que
está coletando o sangue tem dificuldades
em visualizar as veias do braço do paciente.
Uma alternativa é a coleta das veias da mão,
sendo que, nesse caso, as veias de mais fácil
acesso são
Provas
Questão presente nas seguintes provas
No ambiente laboratorial, geralmente
o profissional que realiza o exame não
participou da coleta da amostra, porém,
junto à amostra, há informações sobre o
material coletado. Se uma amostra contém a
informação: secreção endocervical, conclui-se
que essa amostra foi coletada de um sítio
Provas
Questão presente nas seguintes provas
Dentre as opções a seguir, assinale aquela
que NÃO pode ser considerada uma norma
de biossegurança para um laboratório de
análises clínicas.
Provas
Questão presente nas seguintes provas
Cadernos
Caderno Container